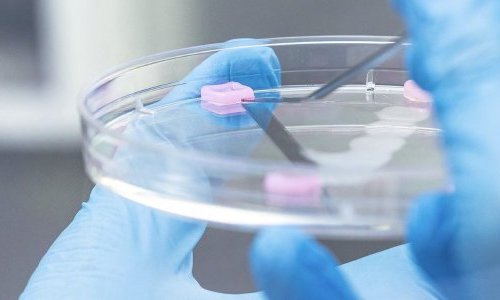

The French cosmetics industry, which brings together 3,500 companies, 80% of which are SMEs, is the second largest contributor to the country’s trade balance. This highly strategic sector for the French economy operates in a growing global market that is attracting more and more countries. In 2021, France was the world’s leading exporter of cosmetics with over 14,5% of the export market. In front of a strong competition from Asian countries, especially South Korea, Japan, and China, France remains the market leader thanks to a dynamic research on the subjects of innovations of the perfumery and cosmetic industry. In such a context, R&D and innovation are key elements to establish the values of the “French brand”.
The Centre-Val-de-Loire region, famous for cosmetics research and innovation
The Centre-Val de Loire region has made cosmetics the core focus of its Regional Innovation Strategy, spawning the COSMÉTOSCIENCES program in 2015. Led by the University of Orléans, the project involves the University of Tours, the CNRS, the Cosmetic Valley competitiveness hub and Le Studium Loire Valley institute. Since 2015, 40 collaborative research projects have emerged, involving various research teams at 35 businesses in the cosmetics sector.
Over 5 years, the combined workforce dedicated to cosmetics research in the Centre-Val de Loire region has reached 120 Full-Time Equivalents and published close on 100 papers. This dynamic allows researchers to promote their skills and expertise with new academic and industry partners in order to set up or contribute to projects with a national or international scope.
Three key focus research areas
The research activities developed within COSMÉTOSCIENCES focus on current cornerstones of the cosmetics industry that best meet consumer expectations: eco-responsible cosmetics, efficacy, safety and “Made in France”.
The program’s three key focus areas for research, development and innovation are:
![]() Naturalness and eco-responsible processes,
Naturalness and eco-responsible processes,
![]() Characterisation of a product’s biological activity and safety,
Characterisation of a product’s biological activity and safety,
![]() Formulation and sensoriality.
Formulation and sensoriality.
COSMÉTOSCIENCES federates 23 research teams from 10 academic laboratories at the University of Orléans, the University of Tours and the CNRS, whose expertise spans the entire cosmetic product value chain.
A unique ecosystem within Europe
COSMÉTOSCIENCES is the only regionally structured cosmetics research program in Europe, the skills and visibility of which are gradually gaining momentum. It is part of a regional dynamic with a strong national and international outreach. European partnerships are being set up to use the network’s expertise to promote innovation within the French industry sector.
To learn more about the COSMÉTOSCIENCES program, visit the website cosmetosciences.fr